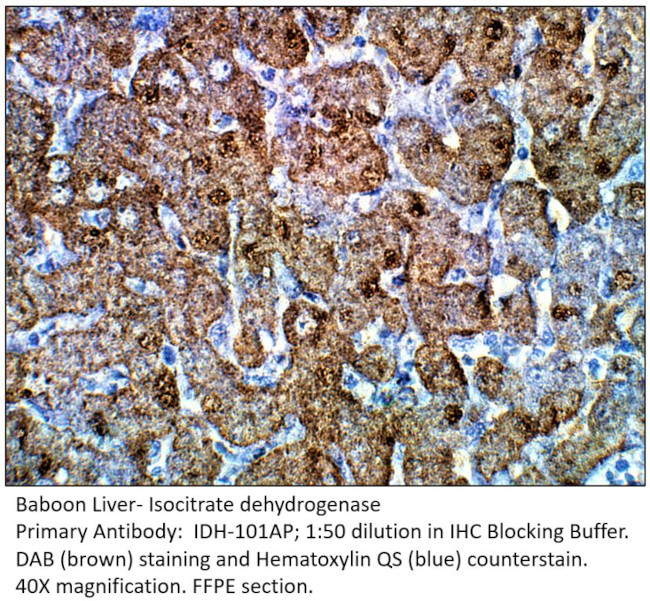
Isocitrate dehydrogenase Antibody in Immunohistochemistry (IHC)

Search
Fabgennix
Isocitrate dehydrogenase Polyclonal Antibody
{{$productOrderCtrl.translations['antibody.pdp.commerceCard.promotion.promotions']}}
{{$productOrderCtrl.translations['antibody.pdp.commerceCard.promotion.viewpromo']}}
{{$productOrderCtrl.translations['antibody.pdp.commerceCard.promotion.promocode']}}: {{promo.promoCode}} {{promo.promoTitle}} {{promo.promoDescription}}. {{$productOrderCtrl.translations['antibody.pdp.commerceCard.promotion.learnmore']}}
产品信息
IDH-101AP
种属反应
宿主/亚型
分类
类型
抗原
偶联物
形式
浓度
纯化类型
保存液
内含物
保存条件
运输条件
靶标信息
Isocitrate dehydrogenases catalyze the oxidative decarboxylation of isocitrate to 2-oxoglutarate. These enzymes belong to two distinct subclasses, one of which utilizes NADas the electron acceptor and the other NADP. Five isocitrate dehydrogenases have been reported: three NAD-dependent isocitrate dehydrogenases, which localize to the mitochondrial matrix, and two NADP-dependent isocitrate dehydrogenases, one of which is mitochondrial and the other predominantly cytosolic. Each NADP-dependent isozyme is a homodimer. The protein encoded by this gene is the NADP-dependent isocitrate dehydrogenase found in the mitochondria. It plays a role in intermediary metabolism and energy production. This protein may tightly associate or interact with the pyruvate dehydrogenase complex.
仅用于科研。不用于诊断过程。未经明确授权不得转售。
篇参考文献 (0)
生物信息学
蛋白别名: ICD-M; IDH; IDP; isocitrate dehydrogenase (NADP(+)) 2, mitochondrial; isocitrate dehydrogenase 2 (NADP+), mitochondrial; Isocitrate dehydrogenase [NADP], mitochondrial; NADP(+)-specific ICDH; NADP+-specific ICDH; NADP+-specific isocitrate dehydrogenase; Oxalosuccinate decarboxylase; unnamed protein product
基因别名: D2HGA2; E430004F23; ICD-M; IDH; IDH-2; IDH2; IDHM; IDP; IDPM; mNADP-IDH
UniProt ID: (Human) P48735, (Mouse) P54071, (Rat) P56574
Entrez Gene ID: (Human) 3418, (Mouse) 269951, (Rat) 361596